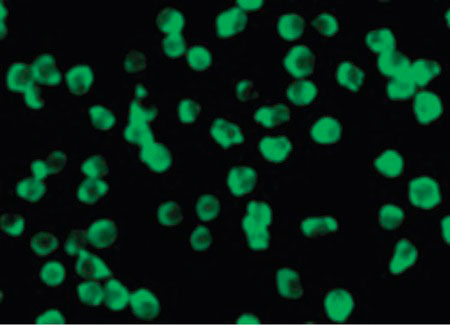

> Antigen, Antibodies, ELISA, Western Blot > Primary Antibody > Polyclonal Antibodies > DAPK3 / ZIP Kinase Antibody (Internal)Brand |
Leading Biology | Catalog Number |
APR02264G |
Product Type |
Polyclonal Antibodies | Field of Research |
|
Product Overview |
We constantly strive to ensure we provide our customers with the best antibodies. As a result of this work we offer this antibody in purified format.
We are in the process of updating our datasheets. If you have any questions regarding this update, please feel free to contact our technical support team.
This product is a high quality DAPK3 / ZIP Kinase Antibody (Internal).
|
||
Molecular Weight |
53kDa
|
||
Cellular Localization |
Antigen Cellular Localization:
Nucleus Cytoplasm. Note=Predominantly localizes to the cytoplasm but can shuttle between the nucleus and cytoplasm; cytoplasmic localization is promoted by phosphorylation at Thr-299 and involves Rho/Rock signaling. Isoform 2: Nucleus. Cytoplasm
|
||
Host |
Rabbit
|
||
Species Reactivity |
Human, Mouse, Rat
|
||
Target |
peptide corresponding to amino acids near the center of human ZIP kinase
|
||
Symbol |
ZIPK
|
||
GeneID |
|||
UniProt ID |
|||
Function |
Serine/threonine kinase which is involved in the regulation of apoptosis, autophagy, transcription, translation and actin cytoskeleton reorganization. Involved in the regulation of smooth muscle contraction. Regulates both type I (caspase- dependent) apoptotic and type II (caspase-independent) autophagic cell deaths signal, depending on the cellular setting. Involved in regulation of starvation-induced autophagy. Regulates myosin phosphorylation in both smooth muscle and non-muscle cells. In smooth muscle, regulates myosin either directly by phosphorylating MYL12B and MYL9 or through inhibition of smooth muscle myosin phosphatase (SMPP1M) via phosphorylation of PPP1R12A; the inhibition of SMPP1M functions to enhance muscle responsiveness to Ca(2+) and promote a contractile state. Phosphorylates MYL12B in non-muscle cells leading to reorganization of actin cytoskeleton. Isoform 2 can phosphorylate myosin, PPP1R12A and MYL12B. Overexpression leads to condensation of actin stress fibers into thick bundles. Involved in actin filament focal adhesion dynamics. The function in both reorganization of actin cytoskeleton and focal adhesion dissolution is modulated by RhoD. Positively regulates canonical Wnt/beta-catenin signaling through interaction with NLK and TCF7L2. Phosphorylates RPL13A on 'Ser-77' upon interferon-gamma activation which is causing RPL13A release from the ribosome, RPL13A association with the GAIT complex and its subsequent involvement in transcript-selective translation inhibition. Enhances transcription from AR-responsive promoters in a hormone- and kinase-dependent manner. Involved in regulation of cell cycle progression and cell proliferation. May be a tumor suppressor.
|
||
Summary |
Serine/threonine kinase which is involved in the regulation of apoptosis, autophagy, transcription, translation and actin cytoskeleton reorganization. Involved in the regulation of smooth muscle contraction. Regulates both type I (caspase- dependent) apoptotic and type II (caspase-independent) autophagic cell deaths signal, depending on the cellular setting. Involved in regulation of starvation-induced autophagy. Regulates myosin phosphorylation in both smooth muscle and non-muscle cells. In smooth muscle, regulates myosin either directly by phosphorylating MYL12B and MYL9 or through inhibition of smooth muscle myosin phosphatase (SMPP1M) via phosphorylation of PPP1R12A; the inhibition of SMPP1M functions to enhance muscle responsiveness to Ca(2+) and promote a contractile state. Phosphorylates MYL12B in non-muscle cells leading to reorganization of actin cytoskeleton. Isoform 2 can phosphorylate myosin, PPP1R12A and MYL12B. Overexpression leads to condensation of actin stress fibers into thick bundles. Involved in actin filament focal adhesion dynamics. The function in both reorganization of actin cytoskeleton and focal adhesion dissolution is modulated by RhoD. Positively regulates canonical Wnt/beta-catenin signaling through interaction with NLK and TCF7L2. Phosphorylates RPL13A on 'Ser-77' upon interferon-gamma activation which is causing RPL13A release from the ribosome, RPL13A association with the GAIT complex and its subsequent involvement in transcript-selective translation inhibition. Enhances transcription from AR-responsive promoters in a hormone- and kinase-dependent manner. Involved in regulation of cell cycle progression and cell proliferation. May be a tumor suppressor.
|
||
Form |
Liquid |
||
Storage & Stability |
Store at +4°C short term. For long-term storage, aliquot and store at -20°C or below. Stable for 12 months at -20°C. Avoid repeated freeze-thaw cycles.
|
||
Applications |
WB, IHC-P, IF, ICC
|
||
Dilution |
IHC-P (2.5 μg/ml), WB (1:500-1:1000),
|
||
Images |

Immunocytochemistry of ZIP kinase in Jurkat cells with ZIP kinase antibody at 10 ug/ml.
Immunofluorescence of ZIPK in Jurkat cells with ZIPK antibody at 10 ug/ml. 
Western blot of ZIP kinase in HeLa (H) and Jurkat (J) whole cell lysates with ZIP kinase... |
||
Specification |
|||
Quantity |
|
||
| Select | Brand | Catalog No. | Product Name | Pack Size | Type | Field of Research | Specification | Quantity | Price(USD) | |
| 1 | Leading Biology | APR03440G | ITGA11 Antibody (N-term) | 100 μl | Polyclonal Antibodies |
|
$495.00 | Add Ask | ||
| 2 | Leading Biology | APR04537G | CMIP Antibody (C-term) | 100 μl | Polyclonal Antibodies |
|
$495.00 | Add Ask | ||
| 3 | Leading Biology | APR12422G | Human H4 Histamine Receptor (extracellular) Antibody | 50 μl | Polyclonal Antibodies |
|
$695.00 | Add Ask | ||
| 4 | Leading Biology | APR03844G | UBE2W Antibody (C-term) | 100 μl | Polyclonal Antibodies |
|
$495.00 | Add Ask | ||
| 5 | Leading Biology | APR04349G | HECTD2 Antibody (N-term) | 100 μl | Polyclonal Antibodies |
|
$495.00 | Add Ask | ||
| 6 | Leading Biology | APR03502G | IGHG1 Antibody (Center) | 100 μl | Polyclonal Antibodies |
|
$495.00 | Add Ask |
 Leading Biology Inc.
2600 Hilltop DR, Building G, B Suite C138
Richmond, CA, 94806
Tel: 1-661-524(LBI)-0262
Email: info@leadingbiology.com
Leading Biology Inc.
2600 Hilltop DR, Building G, B Suite C138
Richmond, CA, 94806
Tel: 1-661-524(LBI)-0262
Email: info@leadingbiology.com
Complete this form and click send to ask us a question, request a quote or simply say hello.

You have 0 item in your cart

You have 0 item in your inquiry list
